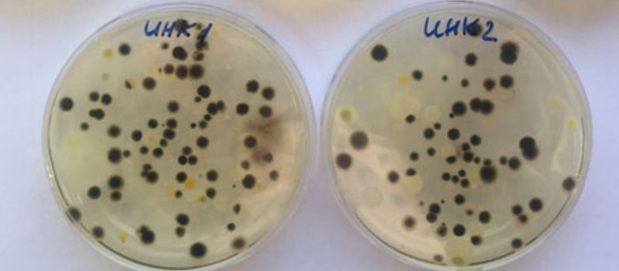
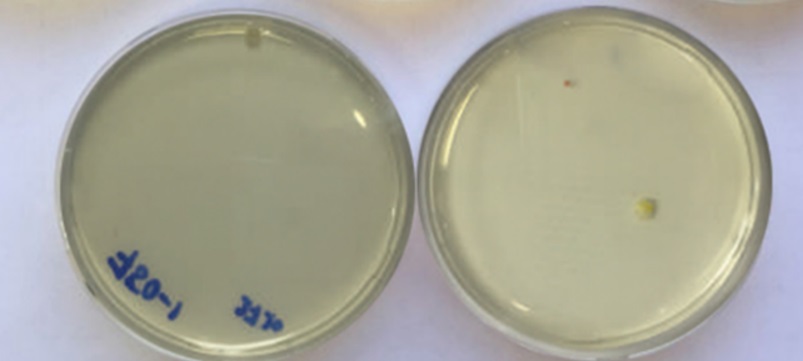

Поток Интер с птицеводами всех стран на ANIMALPROFI

Сергей Субботин, руководитель отдела пищевой промышленности ООО НПФ «Поток Интер», 24-27 августа принял участие в Международном профессиональном форуме ANIMALPROFI, посвященном современным технологиям повышения эффективности в промышленном птицеводстве.
Форум прошел успешно:
- собрались более 200 участников, которые хотят эффективно работать и получать высокие результаты;
- выступили специалисты из 11 стран мира, включая Германию, Нидерланды, Австрию и США – это рекорд для форума;
- прочитано 25 докладов, касающихся самых разных направлений птицеводства, современных тенденций в развитии отрасли.
С. Субботин выступил с докладом на тему «Увеличение сроков годности и другие способы быстрого извлечения прибыли», в котором рассказал, как розничные сети ужесточают требования по сроку годности продукции и какие выходы есть у производителей. Кроме того, в докладе был показан экономический ущерб от негативного воздействия загрязненного воздуха, а также представлены конкретные кейсы внедрения в производственных помещениях систем обеззараживания воздуха «Поток», которые увеличивают срок годности без манипуляций, представляющих опасность для персонала на производстве и конечных покупателей.
Как известно, к возбудителям инфекционных заболеваний наиболее восприимчивы цыплята. Воздушно-капельный (аэрогенный) механизм – один из
наиболее трудно контролируемых механизмов распространения микроорганизмов.
Любая организация или частное лицо заинтересованы в максимальной эффективности и максимальной производительности своего инкубатория или инкубатора. Специалисты бьются над задачей снижения производственных потерь и брака при инкубации яиц.
«Одна из причин потери куриных особей в процессе инкубации – загрязненная микросреда в выводных шкафах и инкубационных машинах. По словам представителей птицефабрик, в среднем 7,5% цыплят гибнут в первые 10-15 дней нахождения в инкубаторах. Эмбрионы, которые погибли на 11−15 сутки, на вид меньше своего возраста, темно-красного цвета — обычно заражены плесенью или другими контаминантами», сообщает Сергей Субботин.
Системы «Поток» снижают перезаражение цыплят в первые часы жизни и увеличивают их выживаемость (% вывода).
Задача-максимум для любого инкубатория — превращение каждого оплодотворенного, качественного, яйца в суточного цыпленка, ведь по предварительным расчетам, с одного миллиона яиц получается дополнительно 2-3% живых цыплят, т.е. прибыль от 4 до 26 миллионов рублей.
Помимо проблем, связанных с увеличением срока годности продукции и снижением количества брака на производстве, одной из самых обсуждаемых тем Форума стало заявление крупнейшей в мире сети ресторанов быстрого питания McDonald’s об отказе от использования в своей продукции мяса
птицы, произведенного с применением антибиотиков. Программа затронет, в первую очередь, Бразилию, Канаду, Южную Корею, Японию, а к концу 2019 года – и Россию.
В США McDonald's еще в 2015 году потребовала, чтобы поставщики мяса птицы поэтапно прекратили откармливать бройлеров с использованием препаратов, которые Всемирная организация здравоохранения (ВОЗ) называет "высокоприоритетными антимикробными средствами, имеющими критическое значение" (HPCIA). К январю 2027 года McDonald's рассчитывает полностью отказаться от курятины с антибиотиками HPCIA на всех рынках, участвующих в программе. Кроме того, компания работает над сокращением содержания антибиотиков в говядине, молоке и молочной продукции, свинине, а также куриных яйцах.



Компания совместно с группой «ПРОДО» повышают качество продукции
Поток Интер представил свою компетенцию на Modern Bakery Moscow